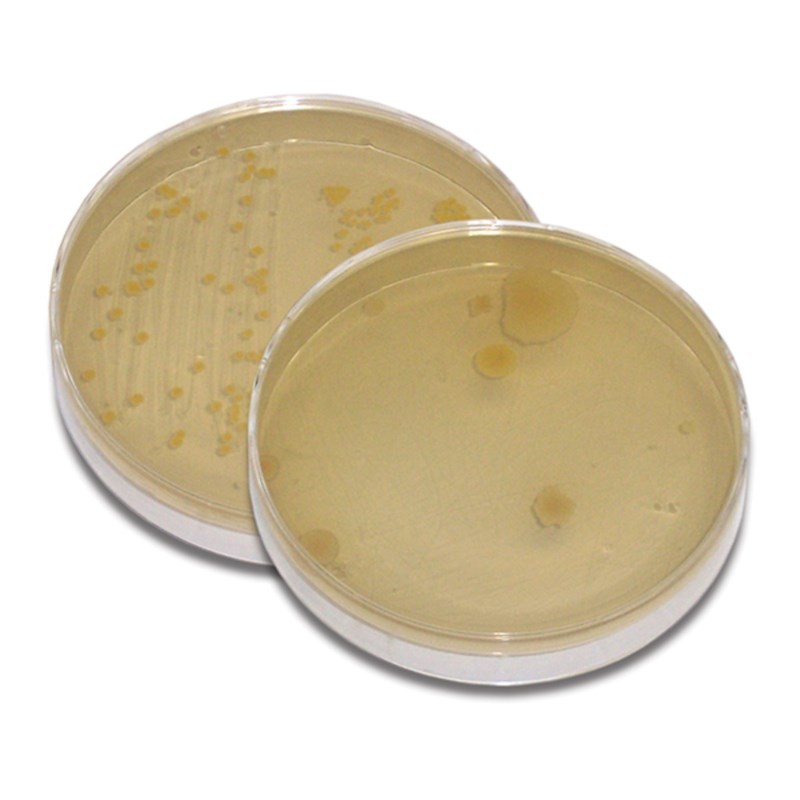

- Alle Preise enthalten MwSt.
- Versandkosten nur € 12,50
- Schulen auf Rechnung
- Große Auswahl
Edvotek - Wie sauber sind Wasser und Luft? # S-30

Vergrößern
Mikroben sichtbar machen mit diesem Wasser- und Luftproben-Set. Erkennung von Verschmutzung und Mikroben einfach und sicher.
WeiterlesenBeschreibung
Lassen Sie Ihre Schüler das Unsichtbare sichtbar machen! Mit diesem Kit können Ihre Schüler Wasser- und Luftproben entnehmen und dann die vorhandenen Mikroben über Nacht züchten. Ein sicherer und einfacher Weg, um Umweltverschmutzung zu demonstrieren.
Hier finden Sie weitere Informationen zum Produkt und Zubehör.
Spezifikationen
| Marke | Edvotek |
|---|